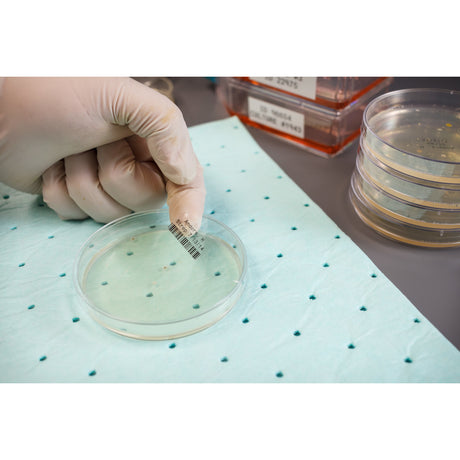
Für raue Umgebungen geeignete Mehrzweck-Etiketten aus transparentem Polyester für M610, M611, BMP61, M710 (mit Medienadapter) und BMP71 (mit Medienadapter)

Brady
Regular price CHF 167.45Unit price /UnavailableBrady
Regular price CHF 251.44Unit price /UnavailableBrady
Regular price CHF 77.18Unit price /UnavailableBrady
Regular price CHF 108.42Unit price /UnavailableBrady
Regular price CHF 90.80Unit price /UnavailableBrady
Regular price CHF 96.32Unit price /UnavailableBrady
Regular price CHF 102.91Unit price /UnavailableBrady
Harsh environment-resistant, multi-purpose transparent polyester labels for M710 and BMP71
Regular price CHF 88.21Unit price /UnavailableBrady
Harsh environment-resistant, multi-purpose transparent polyester labels for M710 and BMP71
Regular price CHF 112.53Unit price /UnavailableBrady
Harsh environment-resistant, multi-purpose transparent polyester labels for M710 and BMP71
Regular price CHF 232.74Unit price /UnavailableBrady
Harsh environment-resistant, multi-purpose transparent polyester labels for M710 and BMP71
Regular price CHF 155.02Unit price /UnavailableBrady
Harsh environment-resistant, multi-purpose transparent polyester labels for M710 and BMP71
Regular price CHF 100.42Unit price /UnavailableBrady
Harsh environment-resistant, multi-purpose transparent polyester labels for M710 and BMP71
Regular price CHF 96.32Unit price /UnavailableBrady
Harsh environment-resistant, multi-purpose transparent polyester labels for M710 and BMP71
Regular price CHF 96.32Unit price /UnavailableBrady
Harsh environment-resistant, multi-purpose transparent polyester labels for M710 and BMP71
Regular price CHF 495.10Unit price /Unavailable